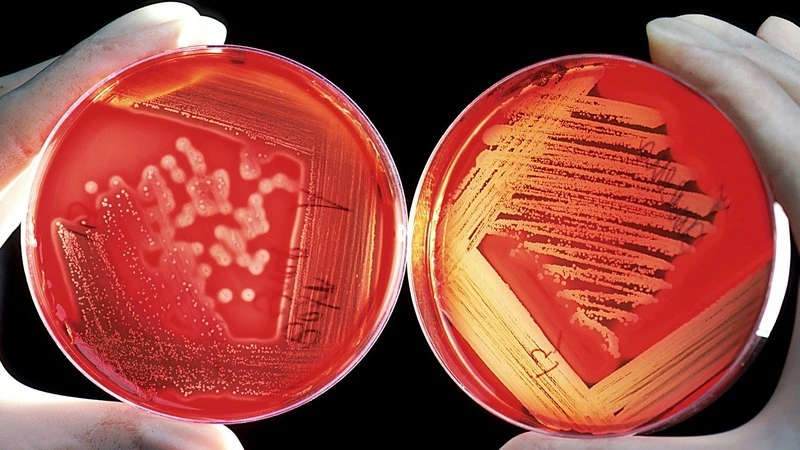
На Сахалине 176 детей и сотрудников садика «Полянка» исследовали на коронавирус

На Сахалине 176 детей и сотрудников садика «Полянка» исследовали на коронавирус
Персонал и 176 воспитанников детсада «Полянка» Южно-Сахалинска прошли тест на COVID-19. Диагностические мероприятия проводятся в связи с выявлением у сотрудника детского сада положительного анализа на инфекцию. Дошкольное учреждение временно приостановило работу, сообщили РИА «Сахалин-Курилы» в правительстве региона.
— Проверяем всех детей, в первую очередь тех, кто был в непосредственном контакте с заболевшим. Проверку должны пройти все сотрудники и дети из этого учреждения, — рассказала Ирина Хегай, заместитель директора лечебного департамента областного минздрава.
Персонал и воспитанники «Полянки» сейчас находятся на карантине по предписанию Роспотребнадзора. Дома с детьми должны оставаться и родители — в ближайшее время всем им также выдадут предписания, которые станут основанием для получения больничного листа.
В самом учреждении проводится санобработка — привлечены сотрудники дезинфекционной станции. Анализы на коронавирус уже сдали все работники детсада и большая часть детей. Осталось проверить еще 82 ребенка. Для забора анализов медики навещают изолированных на дому.
Решение по открытию детского сада будет приниматься после получения результатов анализов и снятия карантина.